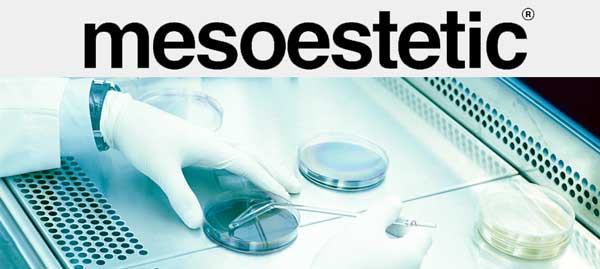
YOLCAN mesoestetic

Inicio > Zelens Skin Science
MICROPIGMENTACION ...

La micropigmentación es una especialidad estética cuyo objetivo es corregir, modificar, embellecer y equilibrar de forma semipermanente determinados rasgos faciales (labios, cejas, párpados, ...) o corporales (cuero cabelludo, areolas mamarias, ...) a través de la implantación de pigmentos a nivel epidérmico.
ESTHEDERM Protección Solar ...

ESTHEDERM ha desarrollado PHOTO CELLULAR CARE, una completa línea de protección solar, a base de filtros minerales, que garantizan una eficacia sin igual.
Nuevas líneas PHOTO CELLULAR CARE
- ADAPTASUN PIEL SENSIBLE. Una línea completa para que las pieles sensibles se bronceen.
- ULTIMATE SUN. El producto para las condiciones de insolación más extremas.
- INTO REPAIR. Solución antiarrugas para las pieles intolerantes.
- PHOTO REVERSE. El primer tratamiento solar antimanchas, especial para pieles con hiperpigmentación.
Diamond Extrem Eye ...

LA CRÈME DE LA CRÈME.
Ingredienes exóticos se alían con la investigación más puntera para crear verdaderos concentrados de lujo. La exquisitez y el brillo del diamante más puro...Así es Diamond Extreme Eye, de Natura Bissé, la crema más exclusiva de la firma, con un único activo energético:
el extracto de artemia salina, un concentrado de energía de origen marino que protege el ADN.
Para el cuidado óptimo de tus ojos.
Es tu secreto ...
Sistema INDIBA ...

La radiofrecuencia regenerativa
El efecto regenerativo de INDIBA, es sumamente beneficioso para mantener una piel joven,capaz de revitalizar su actividad celular, y paliando los efectos debidos al paso del tiempo.
Tratamientos:
- anticelulíticos
- estrías
- doble mentón
- flacidez y arrugas
- postliposucción
- reafirmación de senos
- rictus nasogeniano
Sabías que ...
YOLCAN, Centro Profesional de Estética, fue inaugurado en 1983.
Son pues 25 años de experiencia los que Yolanda Alonso, pone a vuestra disposición.
Un trato exquisito, nuestro saber hacer, aparatología de vanguardia y productos cosméticos de reconocido prestigio, aliados al servicio de tu bienestar...
Convencidos que no puede haber belleza sin salud, te ofrecemos nuestro análisis y consejos estéticos que, con un poco de constancia por tu parte, te harán conseguir el resultado esperado.
Porque somos especialistas en que te sientas satisfecha de tí misma.

mesoestetic | cellulishock

Revolucionario tratamiento anticelulitis
Puesto que en la CELULITIS interfieren muchos factores y se manifiesta de forma diferente en cada persona, lo ideal es tratarla a través de un programa dinámico y personalizado abordando todos sus frentes. Esta es la propuesta de cellulishock.
EFICACIA TRIPLICADA
cellulishock actúa directamente desde tres frentes para romper el proceso de formación de la celulitis y prevenir su aparición:
- Microcirculación: estimula la microcirculación y la permeabilidad capilar lo que mejora la oxigenación y nutrición de los tejidos.
- Tejido adiposo: reduce el número y tamaño de los nódulos de grasa disminuyendo así el volumen del área tratada.
- Tejido conectivo: incrementea la síntesis de elastina y colágeno otorgando firmeza y elasticidad a la piel.
| DINÁMICO | PERSONALIZABLE | COMPLETO | MULTINIVEL |
|---|---|---|---|
| Es un tratamiento que combate la celulitis en función de su tipo (compacta, flacida, edematosa ...) y de su grado de avance | Según el diagnóstico, se realiza un cóctel a medida para cada clienta. Según avanzan las sesiones, su combinación se modifica para lograr drenar, quemar grasa o reafirmar. | Este tratamiento combina técnicas como la quimioexfoliación, la exfoliación mecánica, manipulaciones de masajes drenantes, reductores o reafirmantes, mascarillas corporales ... | Actúa directamente desde tres frentes para romper el proceso de formación de la celulitis y prevenir su aparición. |
mesoestetic | collagen 360º

Collagen 360º intensive cream
Activa la regeneración de colágeno. Máxima reducción de arrugas.
Es una crema de acción intensiva desarrollada a partir de colágeno marino enriquecido, con el objetivo de contrarestar la pérdida de colágeno de nuestro organismo.
Presenta una total compatibilidad con las células cutáneas y es asimilable por todo tipo de pieles. Debido a su bajo peso molecular, penetra hasta la segunda capa de la epidermis para actuar dónde la piel lo necesita.
Collagen 360º eye contour
Efecto relleno sin inyección.
Formulación rica en colágeno hidrolizado de origen marino que redensifica el contorno de ojos sin necesidad de agujas.
Reduce visiblemente las arrugas y líneas de expresión.
Collagen 360º capsuled mask
Innovadora mascarilla facial que proporciona un efecto tensor inmediato. Hidrata e intensifica la regeración celular contrarestando la pérdida de firmeza y la indefinición de nuestros rasgos faciales que se producen a partir de los 35 años.
Collagen 360º elixir
Nutricosmético bebible específicamente diseñado para ayudar a reafirmar la piel desde el interior del organismo, reducir las arrugas y devolverle su luminosidad.
Es un ingrediente bioactivo con propiedades regenerantes y reafirmantes de la piel y un nutriente funcional que ayuda a restablecer el equilibrio metabólico de la piel, favoreciendo la biosíntesis de sus componentes.
mesoestetic | PowerPatch Antiedad - Antibolsas / Antiojeras

Anti-Age Power
Tratamiento cosmético para la piel del contorno de ojos. Eficaz prevención y corrección de los signos del envejecimiento cutáneo como arrugas, patas de gallo, manchas, piel rugosa, laxa y flácida.
Los Power Patch se presentan en un coffret con 5 sobres (cada uno con 2 parches en su interior) y dos frascos de suero cosmético. Tras su aplicación se recomienda el uso del Radiance Bx finishing lines para mantener y prolongar sus resultados.
Eye-Light Power
Tratamiento cosmético para la corrección de bolsas, ojeras e hinchazón de la piel del contorno de ojos, proporcionando un efecto hidratante y reafirmante.
El resultado es una mirada con mayor luminosidad. La piel gana elasticidad, gracias al Ácido Hialurónico, que aporta una hidratación a largo plazo. El extracto de Castaño de Indias estimula la circulación de los capilares, favoreciendo la descongestión de la piel, lo que reduce visiblemente las bolsas y ojeras. Otros ingredientes favorecen la eliminación de líquidos y pigmentos anómalos acumulados en el contorno de los ojos.







